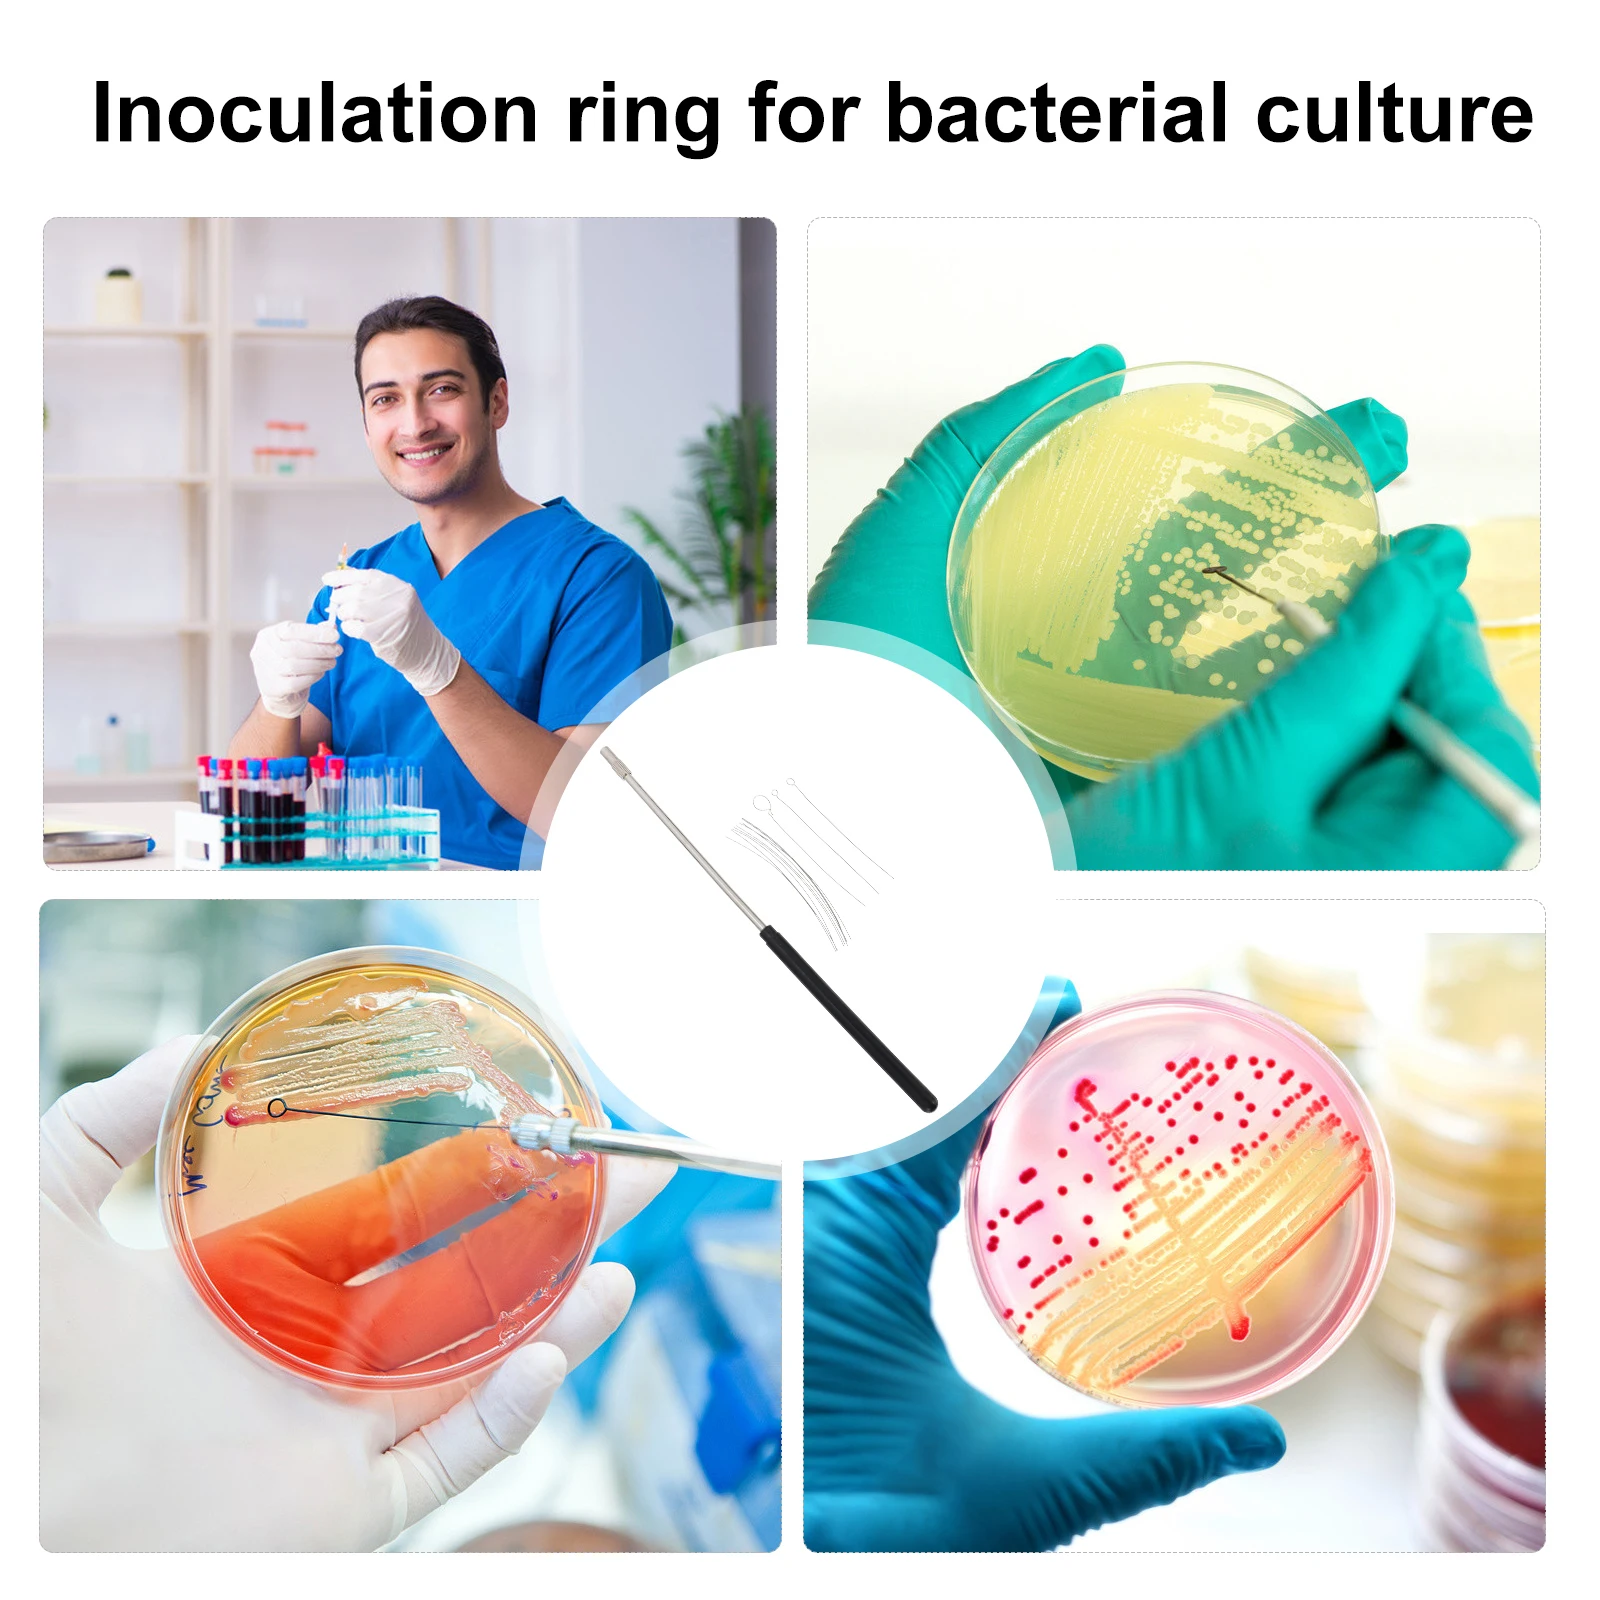
thumb

Copper Inoculation Rods Set Microbiology Lab Tools Material Replacement Loop Kit Laboratory Supplies Accessory Device
Price history chart & currency exchange rate
Customers also viewed

$8.00
Новая разобранная древняя подставка высотой 75 мм, человек-воин, фигурка из смолы, неокрашенная модель, комплект
aliexpress.ru
$1,911.65
Glamorous High End Double Bed Waterproof Whitr Full Size Twin Bed Frame Platform Multifunctional Nordic Litera Household Items
aliexpress.com
$2.77
Waterproof PVC 8Pcs Car Door Stickers Set Kit Technical Reflective Racing Sticker Automobiles Exterior Accessories Vinyl Decals
aliexpress.com
$1,247.04
Linlamlim Multifunctional Genuine Leather Parent-child Bed with Bluetooth Audio and Lamp / Tech Smart Beds Tatami Ultimate Camas
aliexpress.com
$0.83
Xiaomi Mijia Wowstick Wowpad Magnetic Screw Postion Memory Plate Mat 1P+1F+ 1FS Electric Screw-driver Kits Xiaomi Smart Home Kit
aliexpress.com
$2.22
Women Fashion Slim Wide Waistband Elastic Belts Chain Rivet Waistband Female Coat Hige Waist Belt Dress Clothing Decorate
aliexpress.com
$11.51
24Pcs 15AK For Binzel Torch/Gun Consumables Electrode Link Rod Tips Goose Neck Bend For MIG Welding Machine 0.8Mm
aliexpress.com
$11.00
Story Dice Board Game Story Cubes Toys Funny Boxed Story Dice Storytelling Game Story Dice Game
aliexpress.com
$42.97
Новый профессиональный костюм, модный костюм с юбкой, студенческий инструмент, рабочая одежда, офисная одежда, женские костюмы, блейзер, комплект из 3 предметов, топ
aliexpress.ru
$24.56
Dual Circuit Plus Battery Switch Mini Waterproof 6011 M-Series 12-32V 100-300A RV Car Boat Battery Selector Isolator Disconnect
aliexpress.com
$2.86
2 Pcs Pet Water Absorbing Gloves Dog Bath Towel for Dogs Cat Absorbent Drying Cleaning
aliexpress.com
$0.99
100pcs Disposable Eyebrow 5R Needle Caps Plastic Machine Tips Traditional Accessories
aliexpress.com
$4.26
Acrylic Weekly Planner Dry Erase Board Magnetic Fridge Sticker Kitchen Writing Pad Memo Reminder Refrigerator Whiteboard List
aliexpress.com
$2.08
Women Shorts Elastic High Waist Ribbed Design Solid Color Casual Loose Fit Shorts Summer Wide Leg Shorts
aliexpress.com
$9.36
2 Gallon Clear Trash Bags, 120 Count, Strong Unscented Liners for Bathroom, Office & Waste Baskets
aliexpress.com
$6.92
A02M-5Pc Sponge Brush Milk Bottle Cup Glass Washing Cleaning Kitchen Cleaner Tools Cup Cleaning Brush Plastic Short Handle
aliexpress.com